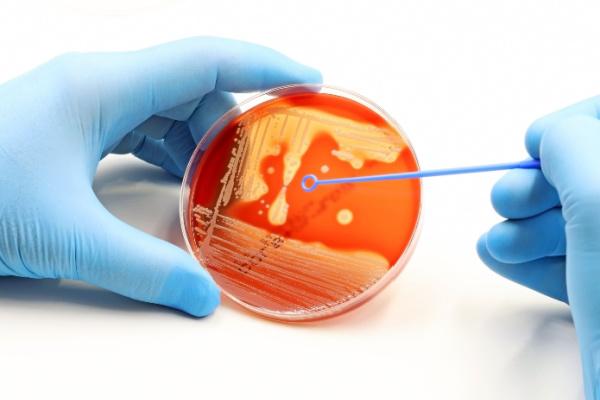
bacteremia

Infectologia
14 fevereiro 2024|

Clínica Médica
14 fevereiro 2024|

Saúde
14 fevereiro 2024|

Medicina de Família
12 fevereiro 2024|

Clínica Médica
12 fevereiro 2024|

Terapia Intensiva
12 fevereiro 2024|

Reumatologia
11 fevereiro 2024|

Patrocinado
09 fevereiro 2024|

Clínica Médica
19 maio 2025|5 min.

Hematologia
6 novembro 2024|4 min.

Endocrinologia
8 setembro 2025|13 min.

Medicina de Família
13 maio 2024|7 min.